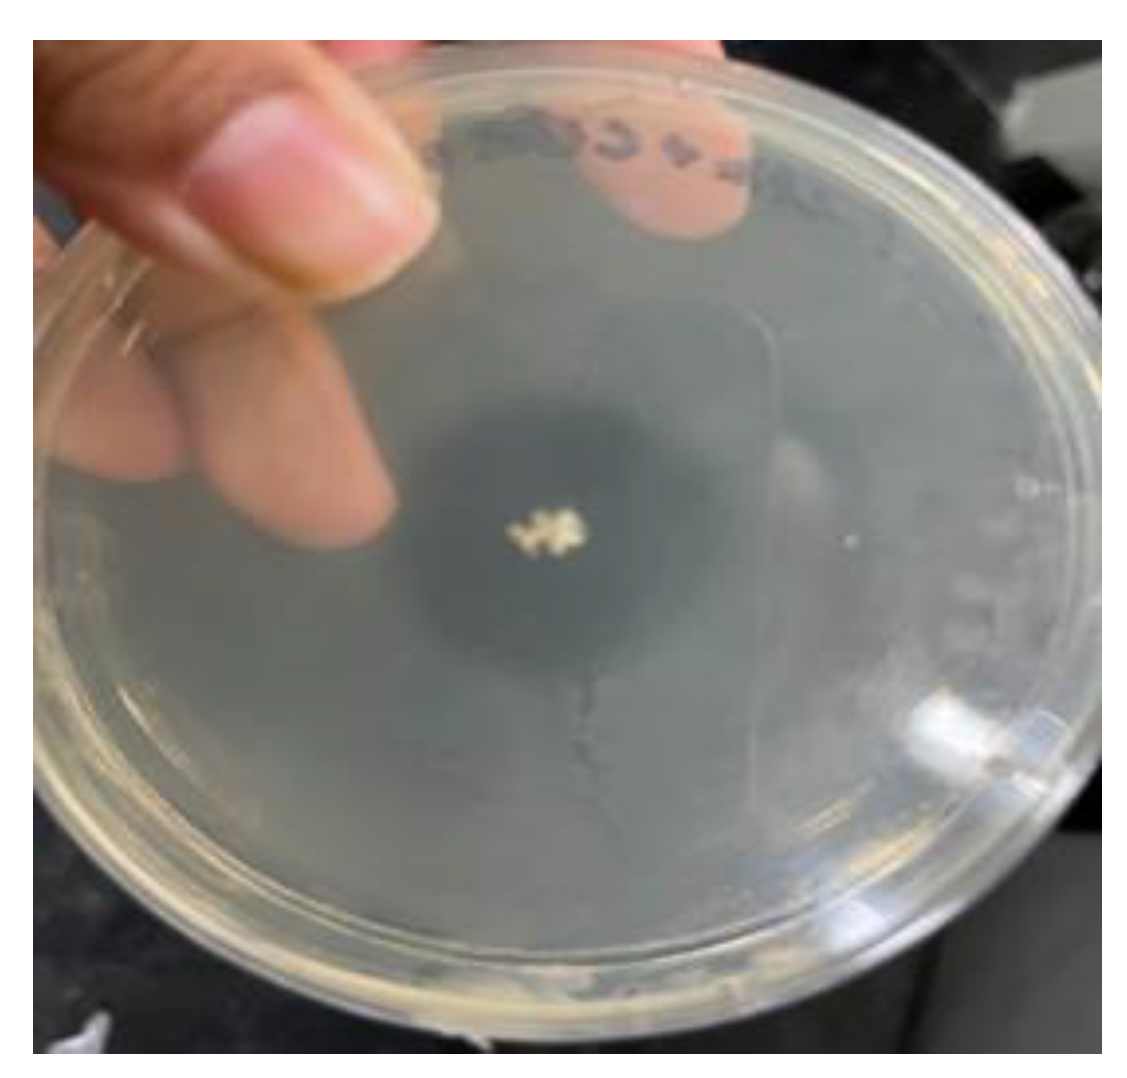

Developing Biopolymer-Based Edible Films with Improved Anti-Microbial Properties †
Abstract
:1. Introduction
2. Materials and Methods
2.1. Materials
2.2. Methodology to Develop Films
2.3. Characterization
2.3.1. Moisture Content
2.3.2. Solubility
2.3.3. Thickness
2.3.4. Transparency
2.3.5. Water Vapor Transmission Rate
2.3.6. Mechanical Properties
2.3.7. Water Contact Angle
2.3.8. Fourier Transformation Infrared (FTIR)
2.3.9. Anti-Microbial Test
2.3.10. Biodegradability and Shelf Life Test
3. Results and Discussions
3.1. Design of Experiment
3.1.1. Moisture, Water Solubility, Thickness and Transparency
3.1.2. Water Vapor Transmission Rate (WVTR)
3.1.3. Water Contact Angle
3.1.4. Mechanical Properties
3.1.5. Fourier Transform Infrared (FTIR)
3.1.6. Biodegradability and Shelf Life Test
3.1.7. Anti-Microbial Properties
4. Conclusions
Supplementary Materials
Author Contributions
Funding
Institutional Review Board Statement
Informed Consent Statement
Data Availability Statement
Acknowledgments
Conflicts of Interest
References
- Abral, H.; Basri, A.; Muhammad, F.; Fernando, Y.; Hafizulhaq, F.; Mahardika, M.; Sugiarti, E.; Sapuan, S.; Ilyas, R.; Stephane, I. A simple method for improving the properties of the sago starch films prepared by using ultrasonication treatment. Food Hydrocoll. 2019, 93, 276–283. [Google Scholar] [CrossRef]
- Cerqueira, M.A.P.R.; Pereira, R.N.C.; Ramos, P.L.S.; Teixeira, J.A.C.; Vicente, A.A. Edible Food Packaging: Materials and Processing Technologies; Taylor Francis; CRC Press: London, UK, 2016; p. 469. ISBN 9781482234169. [Google Scholar]
- Cortes-Rodríguez, M.; Villegas-Yepez, C.; Gonzalez, J.H.G.; Rodríguez, P.E.; Ortega-Toro, R. Development and evaluation of edible films based on cassava starch, whey protein, and bees wax. Heliyon 2020, 6, E04884. [Google Scholar] [CrossRef] [PubMed]
- Falguera, V.; Quintero, J.P.; Jiménez, A.; Muñoz, J.A.; Ibarz, A. Edible films and coatings: Structures, active functions and trends in their use. Trends Food Sci. Technol. 2011, 22, 292–303. [Google Scholar] [CrossRef]
- Fitch-Vargas, P.R.; Aguilar-Palazuelos, E.; Zazueta-Morales, J.J.; Vega-García, M.O.; Valdez-Morales, J.E.; Martínez-Bustos, F.; Jacobo-Valenzuela, N. Physicochemical and microstructural characterization of corn starch edible films obtained by a combination of extrusion technology and casting technique. J. Food Sci. 2016, 81, E2224–E2232. [Google Scholar] [CrossRef] [PubMed]
- Huber, K.C.; Embuscado, M.E. Edible Films and Coatings for Food Applications; Springer: New York, NY, USA, 2009; p. 416. [Google Scholar]
- Lin, D.; Zhao, Y. Innovations in the development and application of edible coatings for fresh and minimally processed fruits and vegetables. Compr. Rev. Food Sci. Food Saf. 2007, 6, 60–75. [Google Scholar] [CrossRef]
- Mellinas, C.; Ramos, M.; Jimenez, A.; Garrigós, M.C. Recent Trends in the use of pectin from agro-waste residues as a natural-based biopolymer for food packaging applications. Materials 2020, 13, 673. [Google Scholar] [CrossRef] [PubMed]
- Montero Garcia, M.P.; Gomez-Guillen, M.C.; Lopez-Caballero, M.E.; Barbosa-Cánovas, G.V. Edible Films and Coatings: Fundamentals and Applications; Taylor Francis; CRC Press: London, UK, 2017; p. 616. ISBN 9781482218312. [Google Scholar] [CrossRef]

| Run No. | Gluten (g) | Castor Oil (g) |
|---|---|---|
| R1 | 0.75 (+1) | 0.125 |
| R2 | 0.25 (−1) | 0.125 (−1) |
| R3 | 0.75 | 0.375 (+1) |
| R4 | 0.25 | 0.375 |
Disclaimer/Publisher’s Note: The statements, opinions and data contained in all publications are solely those of the individual author(s) and contributor(s) and not of MDPI and/or the editor(s). MDPI and/or the editor(s) disclaim responsibility for any injury to people or property resulting from any ideas, methods, instructions or products referred to in the content. |
© 2023 by the authors. Licensee MDPI, Basel, Switzerland. This article is an open access article distributed under the terms and conditions of the Creative Commons Attribution (CC BY) license (https://creativecommons.org/licenses/by/4.0/).
Share and Cite
Kashyap, K.; Sistla, Y.S.; Mehraj, S. Developing Biopolymer-Based Edible Films with Improved Anti-Microbial Properties. Eng. Proc. 2023, 37, 21. https://doi.org/10.3390/ECP2023-14655
Kashyap K, Sistla YS, Mehraj S. Developing Biopolymer-Based Edible Films with Improved Anti-Microbial Properties. Engineering Proceedings. 2023; 37(1):21. https://doi.org/10.3390/ECP2023-14655
Chicago/Turabian StyleKashyap, Katyayani, Yamini Sudha Sistla, and Shumyla Mehraj. 2023. "Developing Biopolymer-Based Edible Films with Improved Anti-Microbial Properties" Engineering Proceedings 37, no. 1: 21. https://doi.org/10.3390/ECP2023-14655
APA StyleKashyap, K., Sistla, Y. S., & Mehraj, S. (2023). Developing Biopolymer-Based Edible Films with Improved Anti-Microbial Properties. Engineering Proceedings, 37(1), 21. https://doi.org/10.3390/ECP2023-14655

